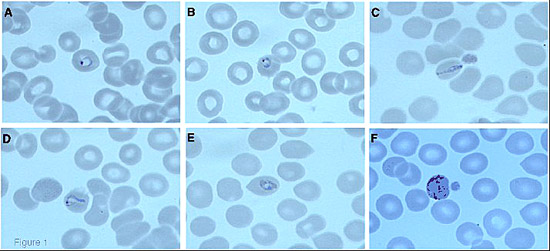

Một khách du lịch người Đức sau khi trở về từ Thái Lan đã nhiễm cả ký sinh trùng sốt rét ở khỉ (Plasmodium knowlesi) và vi-rút HIV. Bệnh nhân 54 tuổi này đã đến khám tại Viện Y học Nhiệt Đới ở Tübingen với tiền sử sốt và ớn lạnh 11 ngày qua.
Vấn đề nguồn nhiễm Plasmodium knowlesi và sự đồng nhiễm sốt rét với HIV
Kết quả xét nghiệm ban đầu bằng kính hiển vi (lam máu giọt đàn nhuộm giemsa) cho thấy bệnh nhân có thể đã nhiễm phối hợp 2 loài KSTSR Plasmodium falciparum và Plasmodium malariae. Tuy nhiên, bằng kỹ thuật PCR khuyếch đại tiểu phần nhỏ ribosome ARN đã cho kết quả bệnh nhân nhễm P.knowlesi là loại ký sinh trùng trước đây chỉ ký sinh ở khỉ. Nồng độ ký sinh trùng trong máu là 473/μl và lượng tiểu cầu ở mức bình thường. Sau khi được chỉ định dùng thuốc uống Malarone® bệnh nhân đã nhanh chóng hồi phục mà không bị biến chứng nào cả. Theo các thủ tục thông thường thì bệnh nhân cũng phải được xét nghiệm HIV và bệnh nhân này có phản ứng dương tính với HIV và số lượng tế bào CD4 là 115/μl trong khi tải lượng vi-rút ở mức 34.799 bản sao/ml máu. Bệnh nhân đã được theo dõi trong 7 ngày tiếp theo và tải lượng vi-rút đã tăng lên 102.000 bản sao/ml. Ba tháng sau lần định lượng đầu tiên thì tải lượng vi-rút đã giảm xuống 10.000 bản sao/ml mà không hề sử dụng một loại thuốc kháng HIV nào cả. Điều này có thể lý giải khả năng bệnh nhân có sự gia tăng tạm thời tải lượng vi-rút HIV do đã nhiễm đồng thời KSTSR P.knowlesi, tương tự như đã có báo cáo trước đây về trường hợp nhiễm đồng thời P.falciparum và vi-rút HIV.
Trong vòng 8 năm qua, có rất nhiều công trình nghiên cứu báo cáo về sự tồn tại của một loài ký sinh trùng (Plasmodium) thứ năm có khả năng gây bệnh sốt rét ở người. Loài KSTSR thứ 5 đó là Plasmodium knowlesi, một loài ký sinh trùng sốt rét vốn chỉ xuất hiện trên loài khỉ đuôi dài (Macaca fascicularis) và khỉ đuôi lợn (Macaca nemestrina) ở khu vực Đông Nam Á. Trong năm 2004, Singh và các đồng nghiệp đã mô tả một ổ dịch lớn đầu tiên những ca nhiễm P. knowlesi tự nhiên ở người tại huyện Kapit bang Sarawak (Đảo Borneo thuộc Malaysia). Từ đó trở đi, rất nhiều báo cáo sau đó cũng xác nhận các ca nhiễm P. knowlesi ở người trên khắp các khu vực từ Borneo thuộc Malaysia đến Bán đảo Malaysia, cũng như là các nước láng giềng ở Đông Nam Á như Myanmar, Việt Nam, Philippines, Thái Lan, Cam-pu-chia, Singapore. Tần suất nhiễm P. knowlesi ở những bệnh nhân có sốt rét được chẩn đoán bằng kính hiển vi dao động từ ít hơn 1% (ở Thái Lan) cho đến 60% (Borneo thuộc Malaysia). Từ năm 2004, người ta đã công bố có 12 ca sốt rét ngoại lai do P. knowlesi xảy ra ở các nước không có SRLH. Mười một trong số các ca đó đã phát triển thành sốt rét không biến chứng và đã được điều trị thành công bằng các loại thuốc chống sốt rét hiện đang được sử dụng, một bệnh nhân đã khỏi bệnh một cách tự nhiên (không dùng thuốc). Tuy nhiên ở khu vực Đông Nam Á đã ghi nhận những ca tử vong do P. knowlesi. Tỷ lệ tử vong trên ca bệnh đã được báo cáo là 2% (bệnh viện huyện) và 11% (bệnh viện tuyến trên). Một nghiên cứu thuần tập tương lai tại một bệnh viện ở Borneo thuộc Malaysia cho thấy những ca nhiễm SRAT do P.knowlesi sau khi đã được điều trị bằng artesunate tiêm tĩnh mạch thì không có ca tử vong nào.
Các báo cáo trước đây cho hay hiện tượng nhiễm HIV làm tăng nguy cơ nhiễm sốt rét và SRAT do P. falciparum. Đồng thời, sốt rét do P. falciparum gây nên hiện tượng gia tăng tạm thời tải lượng vi-rút ở những bệnh nhân có HIV dương tính. Sự tương tác giữa bệnh sốt rét và nhiễm HIV đã được nghiên cứu chủ yếu ở các nước châu Phi trên những bệnh nhân mắc SR do P. falciparum. Hiện tại vẫn chưa có thông tin chính thức nào công bố về sự đồng nhiễm sốt rét do P. knowlesi và HIV. Nghiên cứu này lần đầu tiên mô tả bệnh SR do P. knowlesi trên một ca người lớn nhiễm HIV dương tính với khả năng suy giảm miễn dịch tiến triển.
Trình bày ca bệnh
Một nam giới người Đức 54 tuổi đã đến Viện Y Tế Nhiệt Đới tại Tübingen với các triệu chứng sốt, ớn lạnh và đau đầu dữ dội. 20 ngày trước khi tới Viện này bệnh nhân đã trở về từ một chuyến du lịch 4 tuần tới miền nam Thái Lan thăm người vợ Thái Lan của mình. Hầu hết thời gian ông ta ở lại Phuket và không bao giờ sử dụng thuốc phòng bệnh SR nào cả. Khoảng 11 ngày trước khi nhập Viện, các triệu chứng bắt đầu xảy ra, bắt đầu là sốt đột ngột (ban đầu lên tới 40oC) và ớn lạnh. Sau đó sốt giảm dần, nhưng bệnh nhân tiếp tục bị sốt với nhẹ (khoảng 38,5oC) cho đến khi nhập Viện. Trước khi nhập Viện khaorng 8 ngày, bệnh nhân cảm thấy ngứa ở các chi dưới và ông ta kể đã sử dụng Paracetamol® không liên tục. Khi được khám, bệnh nhân không có dấu hiệu cấp tính nào nhưng lại biểu hiện mệt mỏi. Nhiệt độ cơ thể trung bình 37,4oC và các dấu hiệu sinh tồn ổn định (huyết áp 120/75 mmHg, nhịp tim 86 nhịp/1 phút). Ngoại trừ bệnh nhân cảm thấy đau ở hạ sườn bên trái, kết quả khám thực thể không có gì đáng chú ý. Siêu âm ổ bụng cho thấy lá lách sưng nhẹ (14,1 x 6,2cm). Các xét nghiệm cận lâm sàng cho thấy thiếu máu nhẹ (haemoglobin 12,5 g/dl, bình thường 14 – 18 g/dl), tăng LDH (351 U/l, bình thường <251 U/l) và protein C-reactive (2,39 mg/dl, bình thường < 0,51 mg/dl). Các giá trị huyết cầu tố kháccũng bình thường như tiểu cầu (197.000/μl, bình thường 150.000 – 400.000/μl), bạch cầu (4.100/μl, bình trường 4.000 – 9.500/μl), bilirubin toàn phần (0,8 mg/dl, bình thường <1,2 mg/dl) và creatinine huyết tương (0,9 mg/dl, bình thường 0,6 – 1,1 mg/dl). Các xét nghiệm chẩn đoán nhanh sốt xuất huyết cho kết quả âm tính (Dengue DX IgG/IgM và Test nhanh phát hiện kháng nguyên NS1 và Focus Diagnosis, USA). Lam máu giọt đàn và giọt dày nhuộm Giemsa cho thấy sự xuất hiện của ký sinh trùng sốt rét (Hình 1). Dùng phương pháp Lambaréné đếm lượng ký sinh trùng trong máu khoảng 0,01% (473 ký sinh trùng/μl). Soi lam máu giọt đàn dưới kính hiển vi cho thấy một số KSTSR ở thể nhẫn và có hình thái làm liên tưởng đến KSTSR thể nhẫn của P. flaciparum. Tuy nhiên một vài ký sinh trùng ở giai đoạn tư dưỡng già có các sắc tố haemozoin cũng như là các giao bào có kích thước bằng hồng cầu chưa nhiễm bệnh cũng được phát hiện. Dựa trên những điểm đặc trưng hình thái học thì người ta đã chẩn đoán giả định bênh nhân đó đã nhiễm phối hợp hai loài KSTSR P. falciparum và P. malariae. Bệnh nhân được điều trị bằng atovaquone/proguanil 250 mg/100 mg (4 viên/ngày trong 3 ngày) và đã được nhập viện để theo dõi. Trong suốt quá trình điều trị bằng thuốc chống SR thì ký sinh trùng trong máu biến mất nhanh chóng. Theo dõi các lam máu sau đó cho thấy số lượng ký sinh trùng trung giảm từ 70/μl sau 24 giờ xuống còn 11/μl sau 48 giờ sau khi điều trị. Lượng tiểu cầu sau 24 giờ điều trị là 249.000/μl và sau 48 giờ là 257.000/μl.
|
Hình 1. Các lam máu giọt đàn nhuộm Giemsa có KSTSR P. knowlesi (phóng đại: 100x, ngâm dầu).
Hình A và B cho thấy các ký sinh trùng ở thể nhẫn. Hình C cho thấy một bạch cầu hình dãi băng,
hình D và E cho thấy các ký sinh trùng thể tư dưỡng muộn, và hình F cho thấy một giao bào |
Vì việc xác định bằng hình thể trên lam máu KSTSR chưa chắc chắn, kỹ thuật PCR khuyếch đại tiểu phần nhỏ ARN ribosome đã được tiến hành. Các đoạn PCR đã được giải trình trình tự và công cụ tìm kiếm BLAST trong cơ sở dữ liệu GenBank đã cho kết quả 96% khớp với các chuỗi gene của KSTSR P. knowlesi. Công cụ tìm kiếm BLAST này cũng không tìm ra loài ký sinh trùng trên người nào khác nữa. Bệnh nhân được xuất viện sau 3 ngày trong các điều kiện đã cải thiện.
Ngoài ra, bệnh nhân cũng được xét nghiệm HIV như là một phần trong quá trình theo dõi vào ngày nhập Viện. Lần xét nghiệm gần nhất của bệnh nhân là vào 4 năm trước cho kết quả âm tính. Bây giờ các kháng thể HIV-1 đã được phát hiện bởi phương pháp ELISA và xác định bằng phương pháp tách pro-tê-in (Western blot). Số lượng tế bào CD4 là 115/μl và tải lượng vi-rút là 34.799 bản sao/ml máu. Trong lần phỏng vấn lại bệnh nhân cho biết rằng mối quan hệ với người vợ Thái Lan của ông đã bắt đầu từ 4 năm trước. Vào thời điểm đó cả hai đều đã được xét nghiệm HIV và cho kết quả âm tính. Trong các chuyến thăm hàng năm của bệnh nhân tới Thái Lan hai vợ chồng đã có quan hệ không dùng biện pháp an toàn. Bệnh nhân khẳng định rằng ngoài vợ của mình ra ông không hề quan hệ tình dục với người nào khác trong vòng bốn năm qua. Bệnh nhân cũng không thể nhớ được đã bị căn bệnh gì gợi ý có liên quan tới nhiễm HIV ác tính.
Bảy ngày sau ngày được nhập Viện bệnh nhân được kiểm tra tải lượng vi-rút tại văn phòng bác sĩ ngoại trú và kết quả tải lượng vi-rút tăng lên 102.000 bản sao/ml máu. 11 ngày sau ngày được nhập Viện bệnh nhân được đưa vào diện kiểm tra theo dõi. Việc thăm khám thực thể không cho thấy các kết quả dương tính kéo dài. Tuy nhiên, bệnh nhân tiếp tục phàn nàn bị mệt mỏi và đổ mồ hôi trộm. Các xét nghiệm lam máu vẫn được tiếp tục thực hiện nhưng không thấy KSTSR. Xét nghiệm công thức máu toàn phần cho thấy lượng bạch cầu là 3.200/μl và haemoglobin không thay đổi 12,2 g/dl máu. Các giá trị LDH (Lactate dehydrogenase) và protein C-reactive nằm trong giới hạn cho phép. Các cuộc phỏng vấn chi tiết hơn về lịch sử các chuyến đi của bệnh nhân cho thấy bệnh nhân đã ở lại 3 tuần tại nhà ông ta cùng với vợ ở Phuket. Từ tuần lễ cuối cùng của chuyến đi 4 tuần ông ta đã ở tỉnh Ranong 3 ngày (vùng phía nam biên giới với Myanmar). Ông ta có lưu ý rằng trong khi đi dạo trong những khu rừng địa phương và câu cá ở Biển Andaman và ông ta đã bị rất nhiều vết muỗi cắn. Ông cũng cho biết không hề tiếp xúc với khỉ. Đối với việc điều trị HIV dài hạn bệnh nhân đã được chuyển đến một trung tâm chuyên khoa HIV. Năm tuần sau khi nhiễm KSTSR P. knowlesi tải lượng vi-rút được theo dõi đã giảm xuống còn 17.000 bản sao/ml mà không dùng loại thuốc trị bệnh HIV nào cả. Ba tháng sau khi nhiễm P. knowlesi, tải lượng vi-rút chỉ còn 10.000 bản sao/ml vẫn không dùng loại thuốc chống HIV nào cả. Lượng tế bào CD 4 trong hai khoảng thời gian trên lần lượt là 204/μl và 264/μl máu.
| Ngày 1* | Ngày 7 | Ngày 37 (Tuần 5) | Ngày 87 (Tuần 12) |
Tải lượng vi-rút (bản sao/μl) | 34 799 | 102 000 | 17 000 | 10 000 |
Số lượng tế bào CD4 (tế bào/μl) | 115 | 223 | 204 | 264 |
* Ngày bệnh nhân có sốt rét P. knowlesi nhập viện
Bảng 1: Sự phát triển của tải lượng vi-rút và số lượng tế bào CD4)
Theo các hướng dẫn điều trị chính thức, bệnh nhân đã đáp ứng các tiêu chuẩn sử dụng liệu pháp điều trị kháng retrovirus. Tầm quan trọng của việc dùng liệu pháp này đã được thảo luận với bệnh nhân nhiều lần. Tuy nhiên, ông ta luôn từ chối do quan điểm cá nhân đối với thuốc thông thường và thay vào đó bày tỏ niềm hy vọng vào sự cải thiện tự phát.
Bàn luận từ ca bệnh phát hiện
Các ca nhiễm SR do Plasmodium knowlesi đã được phát hiện tại một số khu vực của Thái lan và chủ yếu ở các khu vực miền núi và biên giới với Cam-pu-chia ở phía đông, Malaysia ở phía nam và Myanmar ở vùng tây bắc. Một nghiên cứu gần đây đã xác nhận sự lây truyền của KSTSR P. knowlesi tại tỉnh Ranong (phần phía nam biên giới với Myanmar), nơi có sự xuất hiện bệnh nhân ở lại trong 3 ngày và rất có thể anh ta đã mắc bệnh. Tỷ lệ mắc mới sốt rét do P. knowlesi ở Thái Lan nhìn chung là rất thấp. Trong số 1874 bệnh nhân có sốt đến khám tại các phòng khám sốt rét trong các khu vực khác nhau ở Thái Lan thì tỷ lệ nhiễm KSTSR P. knowlesi là 0,57%. Tuy nhiên đây là ca nhiễm P. knowlesi ngoại lai thứ hai có liên quan đến du lịch mắc phải tại Thái Lan. Điều này cho thấy ngay cả những người du lịch trong một thời gian ngắn cũng có nguy cơ nhiễm KSTSR P. knowlesi và cũng do các hoạt động du lịch đang gia tăng đến vùng Đông Nam Á, sốt rét ngoại lai do P. knowlesicó thể trở nên quan trọng hơn ở những nước không có bệnh sốt rét lưu hành. Trong suốt giai đoạn phỏng vân ban đầu bệnh nhân cho biết rằng trong chuyến đi của mình anh ta chỉ ở lại Phuket nơi mà sự lan truyền của KSTSR là rất thấp và chưa có ca nhiễm KSTSR P. knowlesi nào được báo cáo. Chỉ khi phỏng vấn lại trong đợt theo dõi thì bệnh nhân mới nhớ lại đã có chuyến đi ngắn ngày tới tỉnh Ranong. Điều này gợi nhắc đến khả năng bệnh SR không xảy ra ở những người du lịch trở về từ Thái Lan, thậm chí trước đó họ có báo cáo đã tới thăm các khu vực có tỷ lệ mắc sốt rét thấp.
Những báo cáo trước đây cho thấy những ca mắc sốt rét do P. falciparum nhiễm đồng thời với HIV thường có hiện tượng gia tăng tải lượng vi-rút tạm thời trong suốt giai đoạn phát triển các triệu chứng SRAT. Kublin và các đồng nghiệp đã miêu tả sự gia tăng tải lượng vi-rút trong suốt quá trình mắc sốt rét có triệu chứng (trung bình tăng 0,42; p<0,0001) và sự sụt giảm sau đó của tải lượng vi-rút trở về mức bình thường tám tuần sau khi điều trị bằng thuốc chống SR. Quan sát tương tự cũng có thể được thực hiện với một ca người lớn nhiễm HIV-dương tính và mắc SRAT do P. knowlesi như trường hợp này. Các dữ liệu cơ sở của bệnh nhân trước khi mắc SRAT thì không có sẵn trong khi việc nhiễm HIV thì mới được chẩn đoán lần đầu. Tuy nhiên, người ta đã giám sát được việc tải lượng vi-rút đã tăng lên không lâu sau khi bệnh nhân nhiễm KSTSR P. knowlesi và sau đó đã giảm vào các lần xét nghiệm theo dõi vào tuần thứ 5 tuần và 12 sau đó mà không dùng liệu pháp kháng retrovirus nào cả. Những phát hiện này đưa đến một giả thuyết rằng có thể là do ảnh hưởng của SRAT do P. knowlesi lên vi-rút HIV đã nhiễm trước đó, và điều đó gây gia tăng tạm thời tải lượng vi-rút như đã được mô tả đối với các ca SRAT do P. falciparum. Tuy nhiên, vì quá trình theo dõi này chỉ ở trên một bệnh nhân nên cần phải có nhiều ca bệnh hơn nữa để chứng minh cho phát hiện này.
Phát hiện này cũng đã làm tăng nghi vấn liệu có sự tương đồng giữa các đặc điểm lâm sàng của ca bệnh nhiễm đồng thời HIV và KSTSR P.falciparum với các đặc điểm của ca nhiễm HIV và P. knowlesi hay không. Phần lớn các ca nhiễm SR do P. knowlesi đều có các triệu chứng SR lâm sàng không biến chứng, nhưng gần đây cũng đã có báo cáo ghi nhận các ca SRAT gây tử vong do loài KSTSR này. Các nghiên cứu cũng cho thấy rằng, ở các ca SR do P. falciparum, việc nhiễm đồng thời với HIV là một yếu tố nguy cơ đã đến phát triển sốt rét ác tính và tử vong. Trong một nghiên cứu thuần tập tương lai tại Nam Phi, các ca nhiễm HIV với lượng tế bào CD4 <200μl có nguy cơ phát triển thành SRAT tăng cao (tỷ suất chênh OR 4,8). Hai nghiên cứu về sốt rét ngoại lai do P.falciparum tại các nước không có SRLH cho thấy SRAT thường xảy ra ở những bệnh nhân có lượng tế bào CD4 <350/μl, (tỉ suất chênh OR lần lượt là 2,5 và 3,2). Giai đoạn lâm sàng của ca nhiễm SR do P. knowlesi được miêu tả ở đây là một ca SR không biến chứng mặc dù bệnh nhân có một số biểu hiện suy giảm khả năng miễn dịch đáng chú ý (115 tế bào CD4 dương tính/μl). Hai nhóm nghiên cứu gần đây đã cho thấy sự gia tăng của tải lượng KSTSR trong máu là một dấu hiệu báo trước nguy cơ SR ác tính (≥35.000 ký sinh trùng/μl và >20.000 ký sinh trùng/μl máu). Lượng ký sinh trùng trong máu quan sát được trong trường hợp này ở bệnh nhân là tương đối thấp (473 ký sinh trùng/μl). Vì thế, giai đoạn không biểu hiện biến chứng của ca bệnh SR này cho thấy có sự quan rõ ràng giữa gia tăng số lượng lớn ký sinh trùng trong máu và mức độ nghiêm trọng của của sốt rét do P. knowlesi. Hiện tượng thiếu máu nhẹ và không có nhiễm a-xít hay suy thận là những triệu chứng thường thấy khi nhiễm SRAT do P. knowlesi.
Thật thú vị khi phát hiện rằng hiện tượng thrombocytopaenia (giảm tiểu cầu), triệu chứng gần như phổ biến trong các bệnh nhân nhiễm SR do P.knowlesi, đã không xảy ra. Tuy nhiên, điều quan trọng là cần lưu ý tới lượng tiểu cầu ở dưới giới hạn của mức trung bình khi nhập viện và gia tăng trở lại sau khi bệnh nhân được bắt đầu cho sử dụng thuốc chống sốt rét. Gần đây có những công bố cho thấy thrombocytopaenia trong BNSR do P. knowlesi bắt đầu cải thiện trong khoảng 24 giờ sau khi điều trị sạch ký sinh trùng, cho thấy có sự liên quan giữa số lượng KST P. knowlesi trong máu và lượng tiểu cầu giảm. Theo đó lượng KST trong máu thấp ở bệnh nhân được mô tả trên đây đã dẫn tới việc giảm tiểu cầu nhẹ. Ngoài ra số lượng tiểu cầu thấp nhất có thể xảy ra trước khi nhập viện do bệnh nhân chỉ được nhập 11 ngày sau khi bắt đầu triệu chứng. Các ca SR do P. knowlesi trước đó đã được công bố không có sự gia tăng hiện tượng giảm tiểu cầu bao gồm một cậu bé trai 11 tuổi mắc bệnh bạch cầu tủy xương mãn tính có sử dụng thuốc imatinib và hai bệnh nhân đã cắt bỏ lá lách. Xem xét các ca trên cho thấy có thành phần liên quan đến yếu tố miễn dịch trong sự phát triển của thrombocytopaenia ở những bệnh nhân SRAT do P. knowlesi. Cũng có những ý kiến cho rằng sự đồng nhiễm giữa SR do P.knowlesi với HIV đã góp phần vào sự biến mất của quá trình giảm tiểu cầu trong ca bệnh này, tuy nhiên chỉ với một ca đơn thuần như thế thì tất nhiên là không thể giải thích được vấn đề đó.
Đây là một trường hợp đầu tiên mô tả bệnh sốt rét do P. knowlesi trên một bệnh nhân người lớn nhiễm HIV với tình trạng suy giảm miễn dịch tiến triển. Bệnh nhân có tải lượng vi-rút tăng tạm thời và đây có thể là do hiện tượng SRAT do P.knowlesi. Mặc dù với tình trạng suy giảm miễn dịch tiến triển nhưng các thông sốt xét nghiệm của bệnh nhân lại không biểu hiện của một ca nhiễm SRAT do P. knowlesi và bệnh nhân này có những triệu chứng của một cơn SR không biến chứng.
Phiếu chấp thuận tham gia nghiên cứu đã được bệnh nhân cung cấp cho việc công bố báo cáo ca bệnh này và có kèm theo hình ảnh. Một bản sao của mẫu đó được cung cấp để chủ bút của bài báo này xem xét.